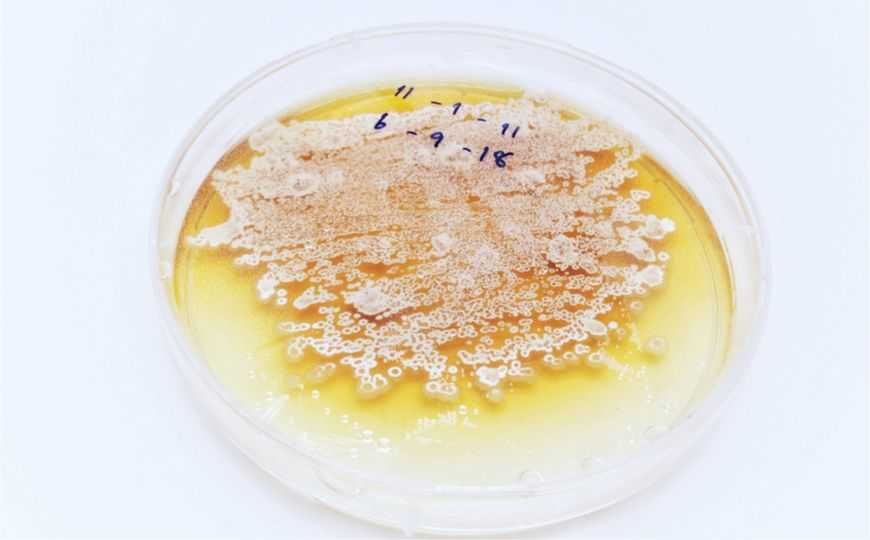

Состав микробиома опухоли может влиять на течение заболевания
У пациентов с карциномой протоков поджелудочной железы исследователи из США и Израиля обнаружили значительный уровень коррелляции между выживаемостью и присутствием в опухоли определённых таксономических групп бактерий. Более того, трансплантация «полезных» групп бактерий от пациентов к модельным мышам с перевитыми опухолями активировала противоопухолевый иммунный ответ у животных. Новые данные открывают возможность манипуляции микробиомом человека в интересах иммунотерапиии опухолей.
Культура стрептомицетов
Credit: chakapong | Shutterstock.com
О взаимодействии микробиома и иммуной системы к настоящему моменту опубликованы тысячи исследований. Вместе с тем, мало какая из этих работ может похвастаться значительным уровнем детализации, позволяющим начать разработку клинически значимой технологии. Новая работа, проведённая консорциумом исследователей из США и Израиля, может привести к использованию естественной микробиоты человека в иммунотерапии одного из наиболее тяжёлых онкологических заболеваний — рака поджелудочной железы. Длительная выживаемость пациентов с этим типом опухоли невысокая, поэтому поиск новых терапевтических подходов в данной области ведётся с большой интенсивностью.
Изучая постоперационный материал, исследователи обнаружили, что опухоли поджелудочной железы колонизированы бактериями. Анализ 16S РНК бактерий, колонизировавших опухоли у пациентов с малой и большой длительностью выживаемости показал существенный уровень корелляции между выживаемостью пациентов и присутствием определённых групп микроорганизмов, в частности, Sachharopolyspora, Pseudoxanthomonas, и Streptomyces. Более того, эта корелляция была подтверждена для двух географически и климатически удалённых групп пациентов — из Балтимора и из Техаса. Интересным фактом явилось и то, что микрофлора опухоли достаточно существенно отличалась от микрофлоры кишечника, однако влияние последней на состав бактерий, колонизировавших опухоль, было достаточно очевидно.
Недавно было продемонстрировано, что микробиом кишечника может оказывать существенное влияние на эффективность иммунотерапии опухолей. Однако воздействие бактерий-симбионтов на опухоли в отсутствие экзогенной терапии не изучалось. В модельном эксперименте исследователи попытались выяснить, является ли обнаруженная корелляция между выживаемостью и составом микробиома отражением каких-то общих, не до конца понятных свойств организма и опухоли, или же определённые типы бактерий действительно могут влиять на развитие опухоли, например, модулируя иммунный ответ.
Микробиом пациентов, характеризовавшихся как длительным, так и сокращённым уровнем выживаемости, перенесли мышам, обработанным антибиотиками с целью подавления собственных симбиотических бактерий. После переноса «фекальных трансплантов», мышам были перевиты сингенные опухоли, полученные от мутантных животных, склонных к спонтанному формированию злокачественных новообразований. Несмотря на то, что трансплантированный микробиом составлял лишь небольшой процент от общего числа бактерий в кишечнике животных, а микробиом, колонизирующий опухоли, значительно отличался от микробиома кишечника и у мышей, и у людей, животные, получившие «полезные» виды микроорганизмов от пациентов с большими сроками выживаемости, имели значительно меньшие опухоли, чем мыши, которым трансплантировали «вредные» бактерии. Более того, у мышей, получивших полезные транспланты, наблюдалось увеличение активности опухолеспецифических Т-киллеров, в то время как вредные микроорганизмы приводили к развитию супрессорного Т-клеточного ответа.
Таким образом, исследователи продемонстрировали, что бактерии могут не только проникать в опухоли, но и самостоятельно, в отсутствие внешних агентов (лекарств) модулировать противоопухолевый иммунный ответ. При этом одни группы микроорганизмов активируют противоопухолевые Т-клетки, а другие, наоборот, вызывают супрессию, активируя регуляторные Т-лимфоциты. По мнению авторов исследования, знание деталей механизмов взаимодействия иммунной системы с микробиомом в контексте противоопухолевого иммунного ответа может иметь не только широкие прогностические, но и значительные терапевтические перспективы, важность которых для пациентов с трудноизлечимыми опухолями поджелудочной железы трудно переоценить.
Источник
Riquelme E. et al. // Tumor Microbiome Diversity and Composition Influence Pancreatic Cancer Outcomes // Cell. 2019 Aug 8;178(4):795-806.e12. DOI: 10.1016/j.cell.2019.07.008


 Меню
Меню





 Все темы
Все темы




 0
0











